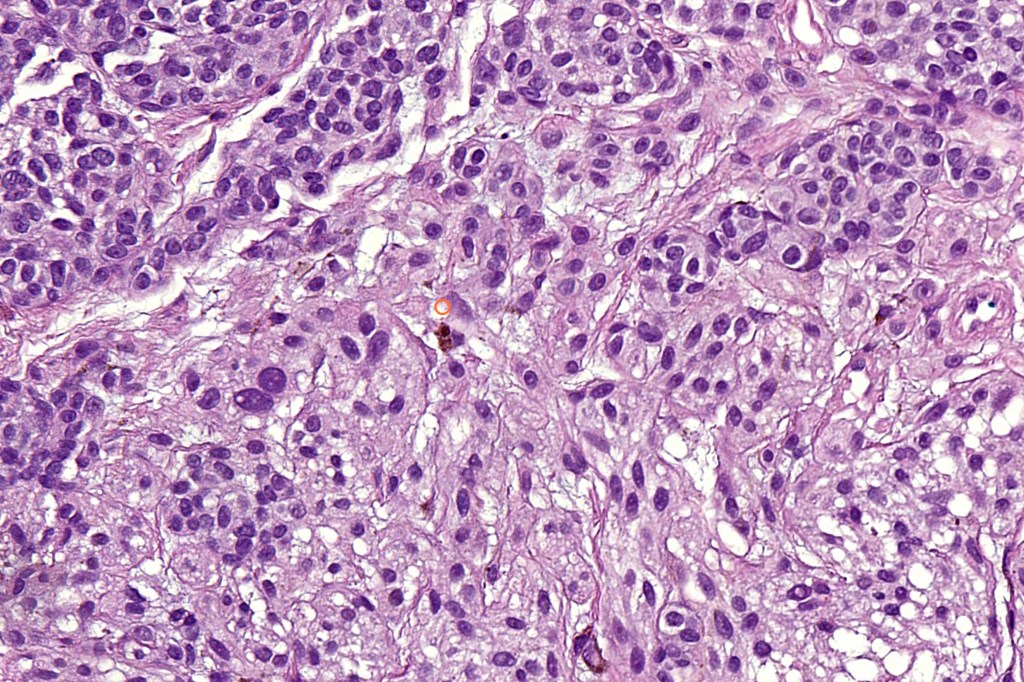
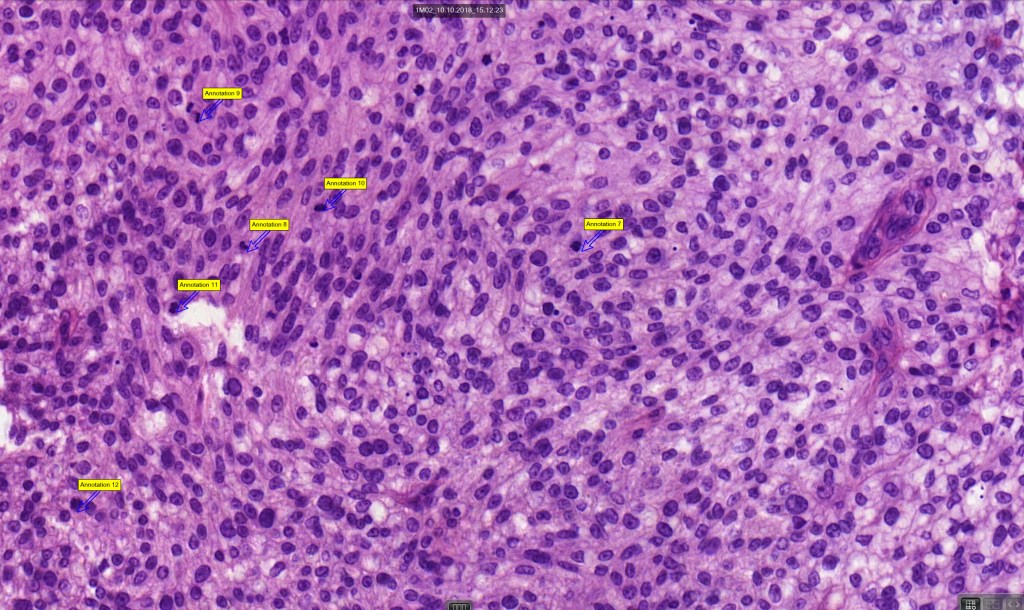
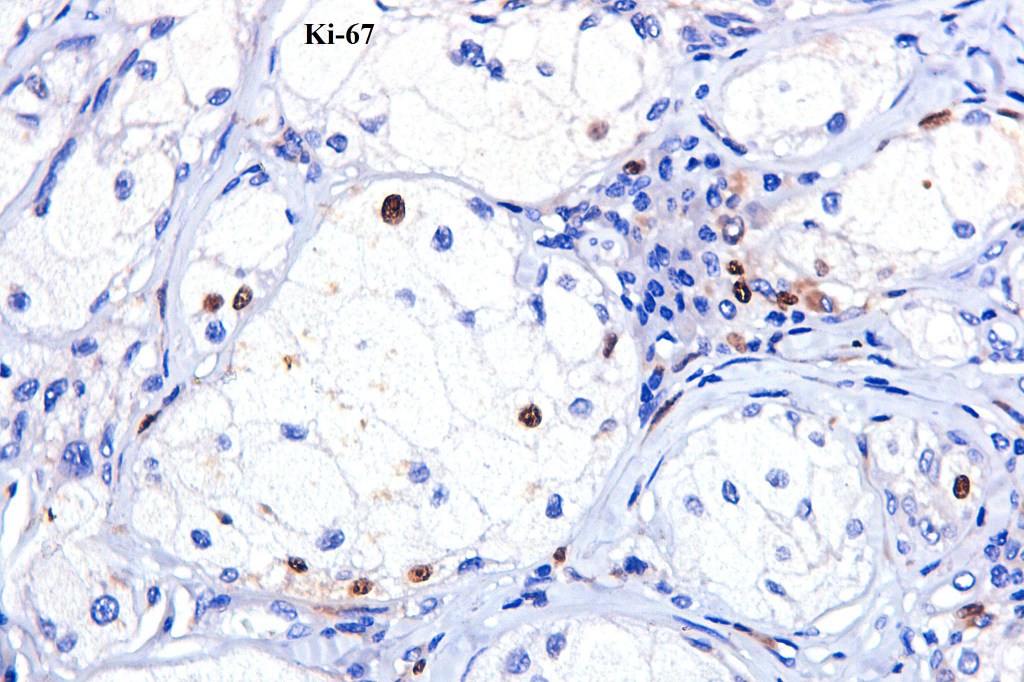
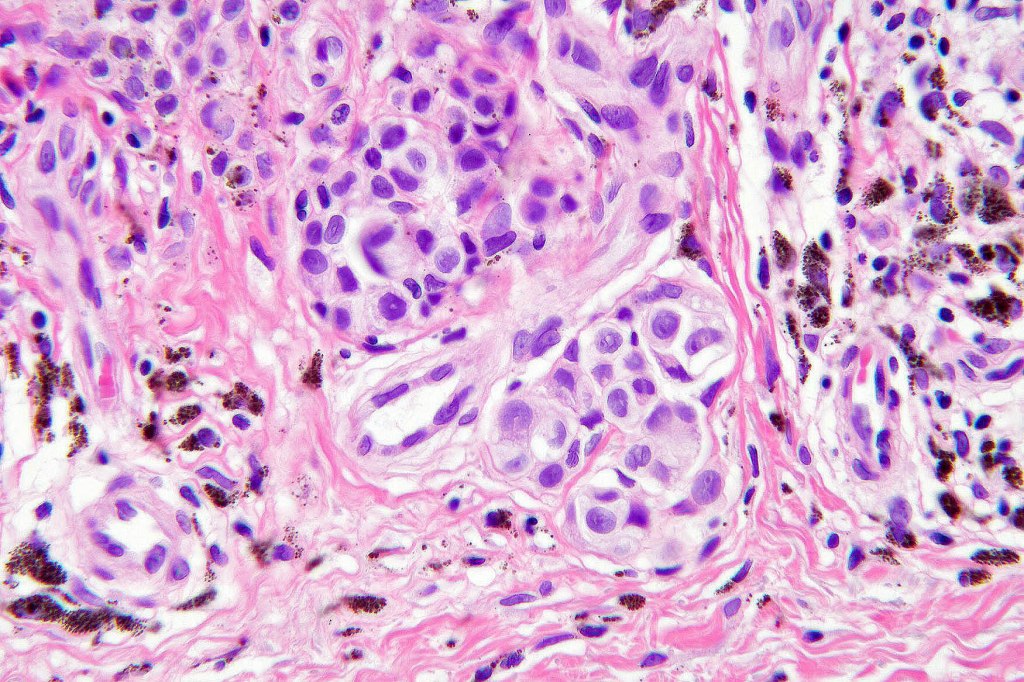
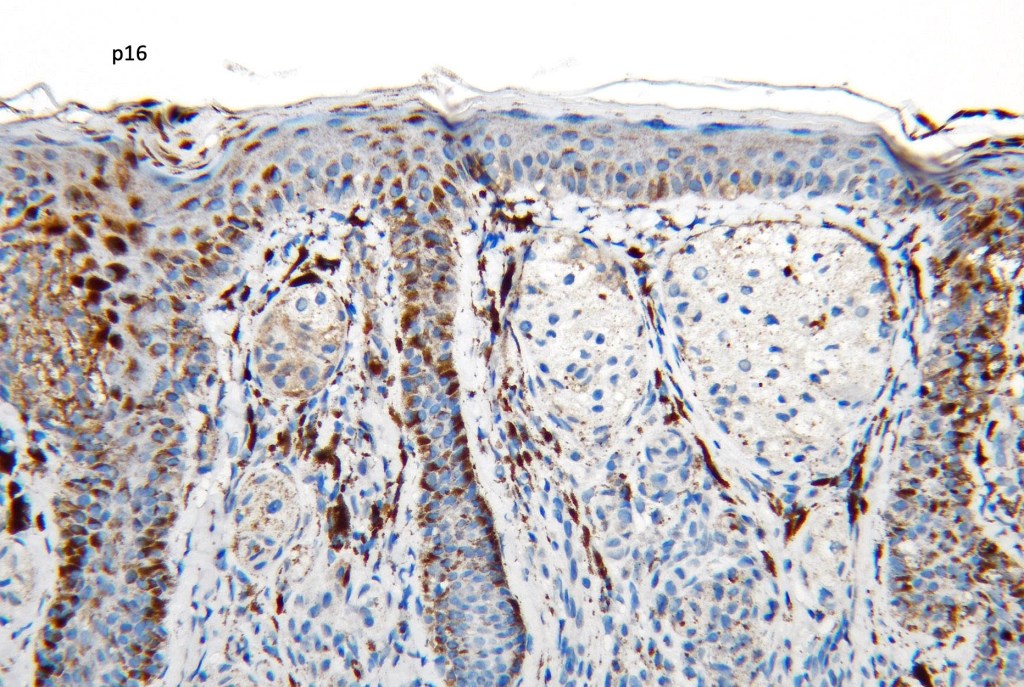
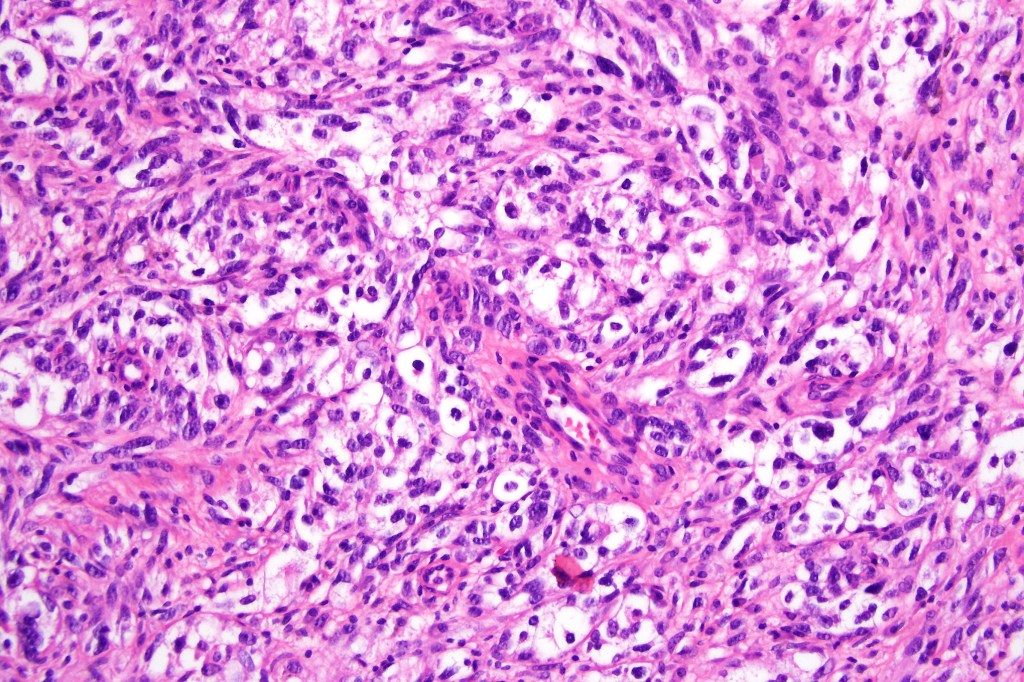
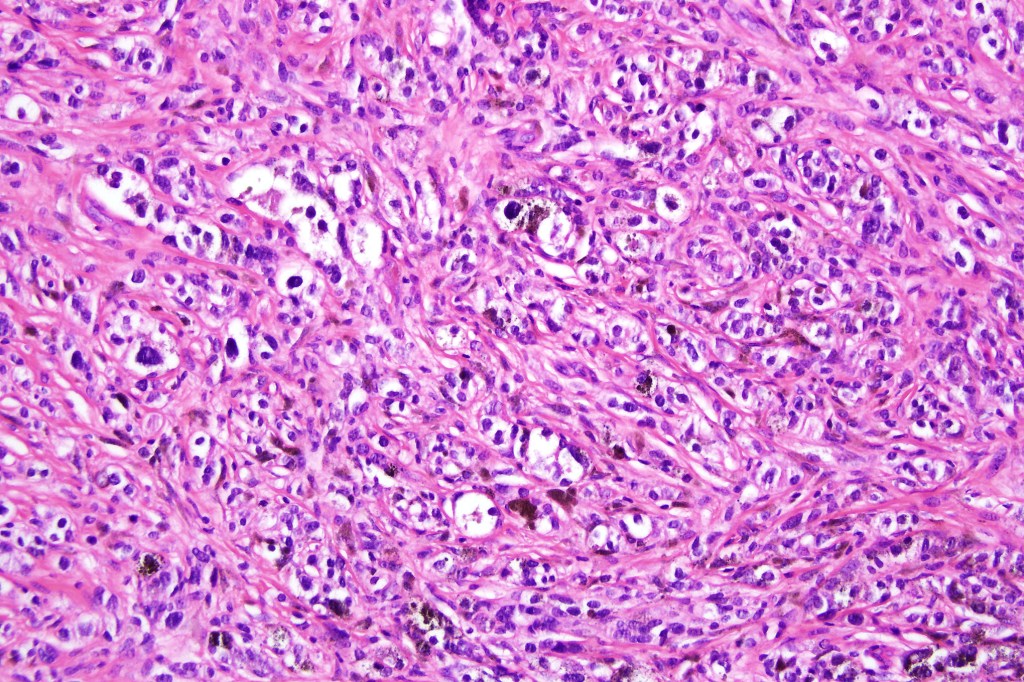
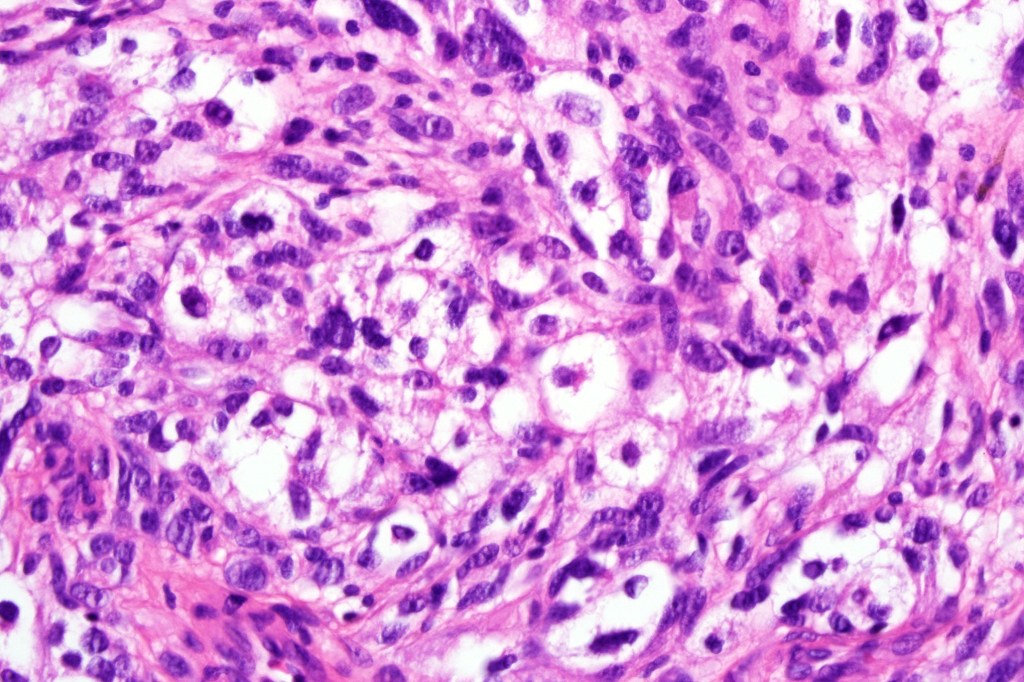
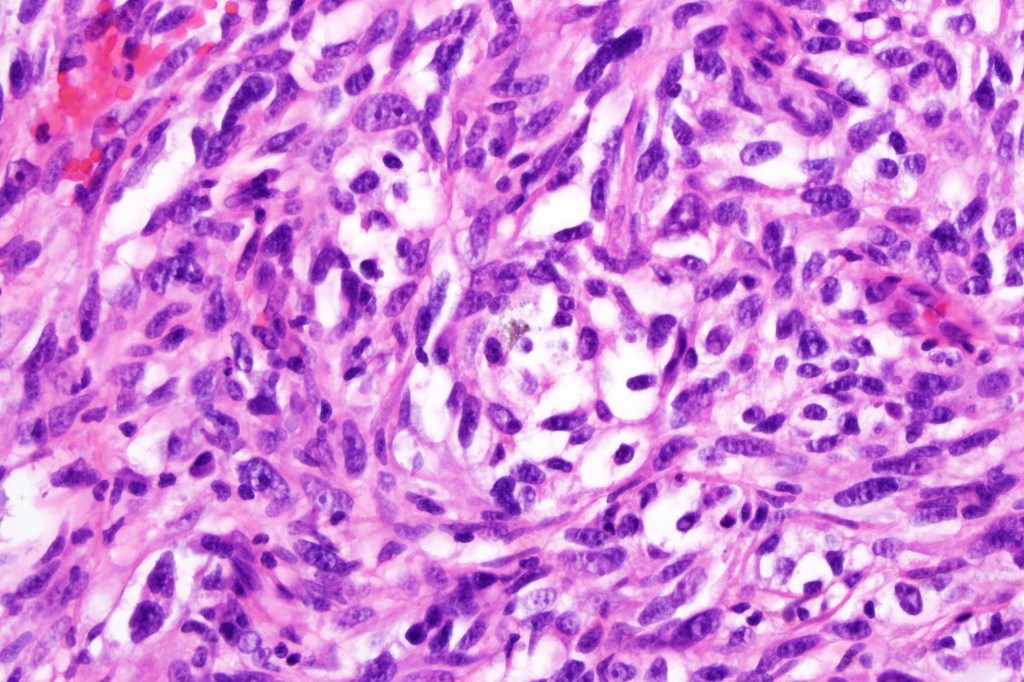

Clinical features
•Very rare variant of melanoma
•M=F
•Middle aged to elderly (mean age 57 years)
•Back> lower & upper extremities> head & neck> choroid
•Often ulcerated nodules
•Balloon cells may be present in a metastasis & not in the primary tumor (and vice versa)
•Poor prognosis is likely related to large tumor size at presentation
Histological features
•May affect the tumor in part or whole
•Enlarged cells with copious eosinophilic, foamy or clear cytoplasm (some authors include melanoma with clear cell change in the same category)
•Variable pigmentation
•Nuclei vesicular or hyperchromatic
•Pleomorphism is not generally marked and indeed can be very subtle
•Variable mitotic activity
•DPAS granules
•Thought to be a result of abnormal or degenerative melanosome change
•Cells stain with HMB45, SOX10, S100, Melanoma-A
•BRAFV600E mutations have been documented
Differential diagnosis
•Balloon cell nevus is the most important differential diagnosis. In my experience balloon cell change in a melanocytic lesion is much more likely to represent a melanoma than a nevus. Lesions should be examined very closely to look for more obvious melanoma, subtle nuclear pleomorphism and mitotic activity before making a diagnosis of balloon cell nevus
•Balloon cell melanoma may also be confused with xanthoma, hibernoma, granular cell atypical fibroxanthoma, sebaceous carcinoma
•Clear cell melanoma should be distinguished from clear cell squamous carcinoma, clear cell sarcoma, metastatic clear cell carcinoma, clear cell hidradenocarcinoma

Leave a comment